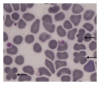

Retrospective and Prospective Investigations about "Quatrefoil" Erythrocytes in Canine Blood Smears
- PMID: 24511413
- PMCID: PMC3913368
- DOI: 10.1155/2014/409573
Retrospective and Prospective Investigations about "Quatrefoil" Erythrocytes in Canine Blood Smears
Abstract
The presence of unusual two RBCs patterns (so-called "quatrefoil RBCs," qRBCs) on canine blood smears at Optical Microscope (OM) was seen during routine evaluation of CBCs. Two consecutive retrospective investigations were arranged including about 7,000 CBCs and clinical records and laboratory data from dogs showing qRBCs. Few samples with qRBCs were prepared for Scanning Electron Microscope (SEM). qRBCs were found in 6.89% (139 of 2016) and 8.47% (133 of 1569) of dogs and in 3.89% (154 of 3,958) and 4.47% (138 of 3,081) of CBCs (some dogs were tested more than once). Statistical analysis was significant for age groups (Chi squared, P < 0.0001), decreased total leukocyte and neutrophil counts (ANOVA, P < 0.0001), RBCs anisocytosis, polychromasia, and Howell-Jolly bodies (ANOVA, P < 0.018, <0.005, and <0.003, respectively). qRBCs were distributed in the area of feathered edge and at the smear side of body-feathered edge area in blood films. SEM ruled out the possibility of an optical illusion or an accidental overlap. qRBCs are associated with ageing of dogs, total leukocyte and neutrophil counts, and RBC anisocytosis, polychromasia, and Howell-Jolly bodies. Few hypotheses were discussed to explain the origin and meaning of this RBC arrangement.
Figures

References
-
- Barger AM. Schalm'S Veterinary Hematology. 6th edition. Ames, Iowa, USA: Wiley-Blackwell; 2010. Erythrocyte morphology; pp. 144–151.
-
- Allison RW, Meinkoth JH. Hematology without the numbers: in-clinic blood film evaluation. Veterinary Clinics of North America: Small Animal Practice. 2007;37(2):245–266. - PubMed
-
- Cowell R, Meinkoth J, Metzge F. The 3 minute blood film-erythrocyte evaluation. Proceeding of the Atlantic Coast Veterinary Conference; 2008; Atlantic City, NJ, USA. Clinical Pathology Section;
-
- DeNicola DB. Hematologic evaluation of dogs & cats I: why is the blood film needed?. Proceeding of the Western Veterinary Conference; 2007; Las Vegas, NV, USA. Clinical Pathology Section; pp. 18–22.
-
- Christopher MM. Erythrocyte shape abnormalities: visual clues to systemic biochemical changes. Proceedings of the 11th European Society of Veterinary Clinical Pathology Conference; 2009; Thessaloniki, Greece. pp. 33–40.
LinkOut - more resources
Full Text Sources
Other Literature Sources